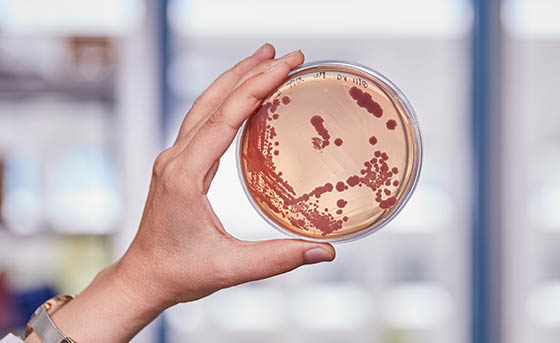

Forschung zum Kunststoff-Baustein Ethylen: Mit Mikroben zu erneuerbaren Kunststoffen
29.10.2025 (wm/red) Dass ein bakterielles Enzym der Schlüssel zu einer nachhaltigen Produktion des Kunststoff-Bausteins Ethylen sein könnte, wird beim Max-Planck-Instituts für terrestrische Mikrobiologie in Marburg erforscht. Die herkömmliche Gewinnung von …
Forschung zum Kunststoff-Baustein Ethylen: Mit Mikroben zu erneuerbaren Kunststoffen Weiterlesen